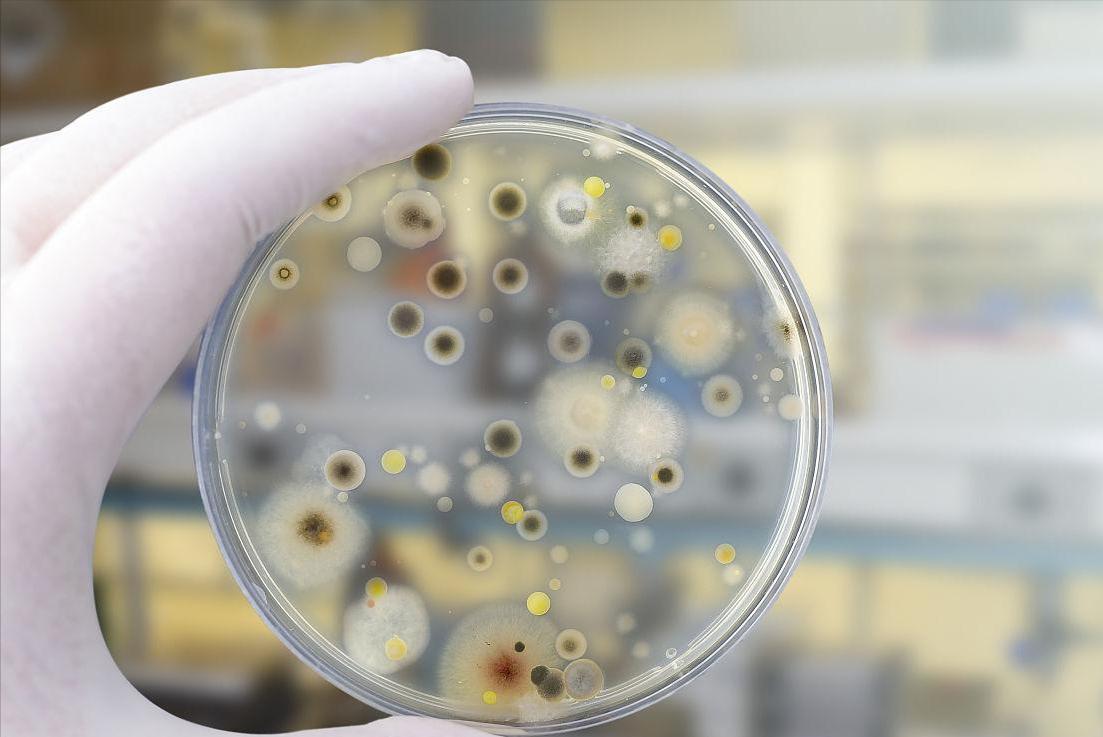
新西兰的几维鸟属于什么类型,新西兰的几维鸟有什么样的形态

北岛褐几维鸟(Apteryx mantelli Bartlett)是新西兰特有的一种鸟类,由于被引进的哺乳动物捕食,目前被列为IUCN分类系统的“易危物种”。
为了限制对幼年几维鸟的捕食,专家们施行了“巢蛋行动”(ONE),在防捕食者的围栏里饲养几维鸟孵下的蛋和幼鸟,直到它们足够大,可以保护自己。

不幸的是,由于具有环境复原力的艾美氏菌卵囊的积累以及巢蛋行动设施中免疫幼稚宿主的密度增加,幼年北岛褐几维鸟的发病率和死亡率推迟了该计划将几维鸟释放到野外的能力。
尽管几维鸟的球虫感染在 1970 年代首次报道,但直到最近才对卵囊和内源性阶段进行深入的形态学描述。

这项研究将继续对这些艾美虫属物种进行形态学描述,并对另一种新的形态学类型验证,进行靶向的COI扩增子测序,提供与其他属成员的区别。

样品采集
本研究选择了来自五个地点的七个北岛褐几维鸟粪便样本,这些样本是在 2017 年至 2018 年间从常规诊断和运输健康筛查中收集的,基于以下因素的组合,包括:
位置、卵囊孢子形成的成功、卵囊负荷、剩余样品量和球虫形态型的多样性。所有七个样本都是使用卫生的一次性收集瓶从室外围栏收集的混合粪便。

所有样品均在室温下保存,并在收集后一个月内送往新西兰北帕默斯顿的梅西大学。抵达梅西大学后,所有掉落的样本都被分配了一个基于位置的代码,以及一个反映单个北岛褐几维鸟宿主或宿主群的识别号。
如果未知,则为该样本分配一个新的标识号。来自同一宿主的重复抽样按提交日期区分。所有球虫阳性的样品均按如下所述处理(见下图)。

卵囊检测、孢子形成和储存
通过使用 Mini-FLOTAC 技术筛选样品中的球虫,卵囊按照Duszynski和Wilber的描述进行孢子化。

然后将少量的粪便与2%水溶液重铬酸钾的比率调为 1:5,在将这些混合物薄薄地分布在培养皿的底部,确保氧合后,将样品在室温下孵育15天。
最后加入蒸馏水以保持内容物湿润,并在孵育期间定期搅拌以进行气体交换。为了确保实验的严格性,研究员会将孢子卵囊在室温下储存在25ml密封烧瓶中。
孢子卵囊分离和测量
将1.5ml微量离心管中的18ml等分试样旋转1分钟以形成沉淀。然后除去上清液涡旋再次离心,最后重复冲洗4-6次,直到上清液无色,接下来向管中添加500μl硫酸镁溶液。
用一次性移液管均质化样品并静置至少1分钟。将这种混合物的液滴悬挂在腔载玻片上的盖玻片的底部,盖玻片用水暂时粘附在腔环上。

使用光显微镜和50.1mm载物台千分尺校准,在多个焦点的油浸下拍摄单个卵囊的照片。测量形态特征时,按照研究指南可以看到多达84个卵囊,而只有当整个长度聚焦时,才用测量孢子囊。

分子分析中脱氧核糖核酸的提取
将形态学描述(n = 0)中包含的等分试样品在-80°C下储存12-24小时;在每个温度下在液氮和3°C之间循环100次5分钟;并与40μl 蛋白酶K在56°C下混合打开未孢子的卵囊壁。
最后使用土壤微生物DNA迷你制备试剂盒提取DNA。

扩增子在含有Invitrogen超纯琼脂糖的琼脂糖凝胶上运行,并使用RedSafe核酸染色溶液进行可视化。使用 PCR纯化试剂盒纯化具有正确大小条带的样品,然后进行初始Sanger测序。如果其中一个或两个读数的ABI%质量得分低于50%,则对样品进行再扩增并进行重测序。
本研究获得的COI序列和从GenBank数据库获得的61个参考序列包括:弓形虫,犬新孢子虫,进行比对后把它们分别修剪为 5 个碱基。然后就可以使用具有93个重复距离的模型来计算分支长度。

实验结果
总体而言,本研究测量了来自混合棕色北岛褐几维鸟粪便的191个卵囊。所有样本都含有混合感染,每个样本的形态型从两到五种不等,并且所有先前描述的艾美虫属都被鉴定出来。没有单一形态型与特定样品相关联,唯一包含五种形态型的样本包括一个类似于先前表征的副尿肠杆菌的单个卵囊。

在为本研究表征的卵囊中,有84个形态相似的卵囊,命名为艾美虫属paopaoii。
就本研究而言,不符合已有研究报告的物种描述。北岛褐几维鸟球虫,这种新颖的第五个形态型,有一个光滑而不是条纹的壁。

这种定性区别在油浸下是可靠的,在较低的放大倍率下偶尔可以辨别。除了这种新颖的形态型外,本研究中对曼氏E. mantellii和E. apteryxii的测量表明,这些形态型的大小比以前描述的要少。据报道,曼泰利埃氏杆菌的平均尺寸为17.9 x 10.7μm ,而当前研究报告的平均长度为 18.8 x 13.9μm。

虽然这两个报告的大小相对相似,但L/W比率提供了更好的形状指标,并指示总体差异。这种不一致体现在曼氏桫椤和桫椤之间L/W比的重叠增加。

实验结果分子分析
COI方案提供了足够的扩增以产生高质量的色谱图,尽管在七个样品中的三个样品中存在重叠的峰,表明与多个艾美菌属同时感染,并且Immucox育种者和层对照。新型北岛褐几维鸟艾美氏菌分离株(K1-7)已提交NCBI数据库。共识序列证实,所有七个样品的球虫和Immucox®育种者和层对照产生的序列属于Eimeria属。

然而,从基督城野生动物园收集的样本K4获得的序列与小鼠球虫序列相似1%,并与另一种小鼠球虫恶性艾美氏菌。
因此,除了K4可能是环境污染外,其余六个北岛褐几维鸟球虫序列分为三个主要簇,这些簇被分组为A-C簇。这种聚类包括从1到16的模糊基数,出现在其中四个序列中。

序列中簇A含有K2和K3,其核苷酸序列同一性为95%。该集群中的样本来自玛纳瓦图地区。
集群B包含K6和K7,它们共享98%的身份,两者都起源于怀卡托地区。

怀卡托地区
对于所有集群来说,包含K1和K5的集群C分歧最大,这些核苷酸序列彼此之间或本研究中的任何其他样品的相同程度不超过93%。
除K4外,北岛褐几维鸟样本与该COI位点的记录没有强核苷酸序列同一性。最相似的核苷酸序列来自K2,与来自澳大利亚的有1%的相同。
在这项研究中,从北岛褐几维鸟的七个混合粪便样本中报告了五个艾美氏形态型,其中描述了一种新的形态型

应该注意的是,与已有的实验例子相比,本研究中报告的几种艾美虫属物种存在一些大小和形状变化。这种差异可能是由于本研究中测量的卵囊数量有限,而Morgan等人提出的样本量更大。
预计随着每个物种鉴定和测量的卵囊数量的增加,误差程度将降低,从而改善形态鉴定。因此,增加这些数据应被视为这些物种特征的延续,因为这些差异可能反映了自然变化。

此外,本报告中这些形态型的例子之间的主要区别在很大程度上取决于缺乏可见的小细胞。目前或以前的研究仍然有可能依赖于增加或减少未观察到的小细胞。
用于成像的卵囊分离的差异也可能对表征产生影响。例如,卵囊的完整性可能受到浮选溶液渗透压的影响,这种效应随着卵囊暴露的时间越长而增加。

同样,尽管研究员使用了与本研究相同的方法,但本报告中添加艾美虫属新形态可以反映操作员的变化。然而,光滑和粗糙的壁之间出现明显的差异证实了北岛褐几维鸟中至少存在五种形态型。
有趣的是,在这些样本中只鉴定出一个副尿肠杆菌卵囊,而在检查的所有样本中却都能鉴定出它。曼氏杆菌存在于本研究中检查的71%的样品中,而以前只有17%。

在这些报告之间,E. apteryxii和E. kiwii的患病率相似。患病率的这种变化表明感染北岛褐几维鸟的球虫的物种组成可能随时间和地点而变化。
COI基因提供的分化证实了北岛褐几维鸟中存在新型的艾美氏菌。序列分组在簇A-C中,可能代表此处报道的两种或两种以上的形态物种。不幸的是,Sanger测序往往只导致检测最常见的序列。
然而,将形态学数据与最常见序列的百分比身份相结合,可以在形态型和特定序列之间进行预测。

例如,分支A中K3和K2中的样本最相似,具有3%的同一性。样品K98主要含有2%的卵囊,而样品K47仅含有3%的卵囊。 因此,K4序列可能代表E. apteryxii,因为它只包含一个模糊的碱基。
成功测序COI基因靶标的样品中有一半(n = 3)包含许多模糊区域,支持存在混合感染。序列之间的相似性使样本之间有足够的变化,以提供北岛褐几维鸟中球虫物种之间有意义的比较,以便进一步进行诊断测试和使用。

小样本量和COI测序结果中的歧义数量鼓励进一步研究这些北岛褐几维鸟的遗传变异。增加样本量和范围将鼓励更多地代表感染北岛褐几维鸟球虫的多样性。鼓励进行更深入的测序分析,以更真实地表示样本内部和之间的变异。
在没有实验感染的北岛褐几维鸟的情况下,最好的替代品是单卵囊测序,它允许形态型和特定序列之间的明确联系。

这项研究提供了对北岛褐几维鸟球虫遗传变异的见解,并证明了研究北岛褐几维鸟球虫的复杂性。本研究中包含的样本均来自圈养或托儿所的少量北岛褐几维鸟,因此可能无法反映整个新西兰发现的变化。
此外,“巢蛋行动”设施经常容纳多种北岛褐几维鸟,宿主特异性知识将确定北岛褐几维鸟通过围栏交叉污染接触新型高致病性艾美氏菌种的风险。

这种对幼稚种群的引入不仅会导致北岛褐几维鸟的繁殖成功率下降,还可能导致引入一种入侵寄生虫,这种寄生虫可能胜过地方性的艾美虫属。因此,应优先考虑其他奇异鸟物种的球虫特征。
此外,开发快速、非侵入性、高度特异性的工具来监测治疗效果,对于确保“巢蛋行动”明智地使用资源至关重要。
这样的工具需要尽可能多地考虑北岛褐几维鸟球虫的变化,以确保稀有但高毒力的物种不会被忽视。但必须使用更深入的测序技术,否则可能会错过这种变化。

参考文献:
1.巴尔韦伯,L.R,贝格内特,F.,马尔基翁德, A(2014):美国兽医寄生虫学家协会对兽医粪便浮选方法和影响其准确性和使用的因素的回顾.
2.科克,S. M.,波姆罗伊,W. E.,豪,L.,麦金尼斯,K.,Vallee,摩根,K. J(2020):比较Mini-FLOTAC和离心粪便浮选对球虫(艾美尔氏菌)的检测.